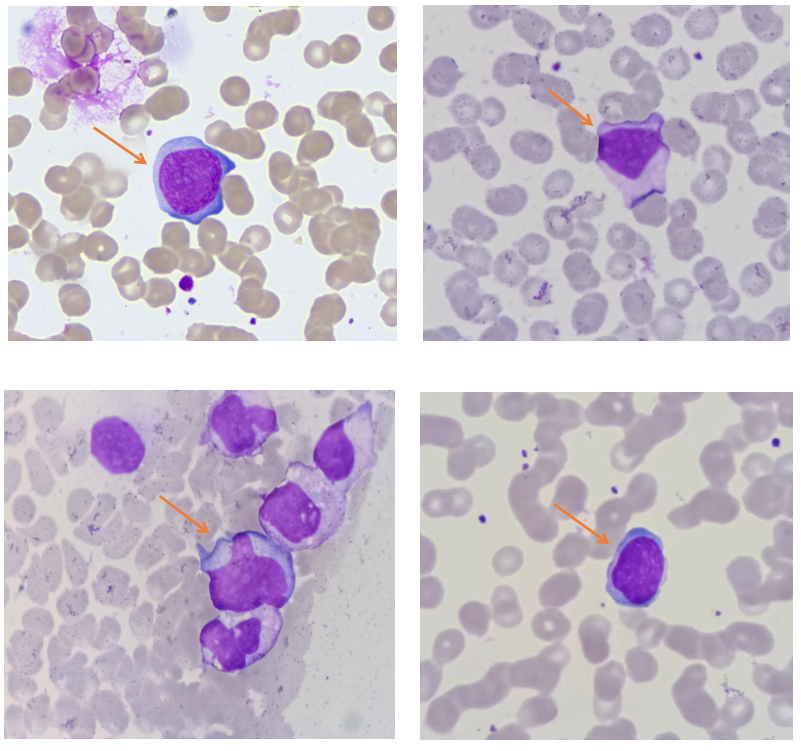
微信图片_20220830151745.png

近日,一名8岁儿童因发热、颈后淋巴结肿大、咽峡炎到社区医院就诊,医生进行头孢曲松钠+炎虎宁+维c治疗,但治疗四天仍高烧持续39℃未见缓解。第五天到西安区域医学检验中心进行血常规、C反应蛋白及肺炎支原体抗体两项、肺炎衣原体抗体两项检查。
血常规结果如下:


血常规结果显示淋巴细胞计数及百分数明显升高,散点图淋巴细胞区域异常。 查看仪器报警提示:异型淋巴细胞?原始细胞/异常淋巴细胞?触发镜检规则推片镜检,镜下可见如下图所示的异型淋巴细胞,占比8%。 肺炎支原体抗体两项、肺炎衣原体抗体两项检查结果如下: C反应蛋白检测结果如下: 根据肺炎支原体IgG抗体168AU/ml,其他三项结果阴性;同时C反应蛋白(29.5mg/L)结果升高并不明显,以及血常规中性粒细胞百分数降低,应用抗菌药物后症状未缓解,初步排除细菌性感染。 但异型淋巴细胞占比8%,且淋巴细胞计数及百分比明显升高,引起检验人员高度重视,怀疑是传染性单核细胞增多症(infectious mononucleosis,IM)。及时联系临床医生,建议加做EB 病毒六项,结果如下: 检测结果显示:EB病毒衣壳抗原IgM抗体>160.0U/ml、EB病毒衣壳抗原IgG抗体94.7U/ml、EB病毒早期抗原IgM抗体阳性、EB病毒衣壳抗原IgA抗体阳性。 因此,综合以上检查结果初步判断是EB病毒感染。 传染性单核细胞增多症(infectious mononucleosis,IM)是一种常见疾病,为一种单核-巨噬细胞系统急性增生性疾病,EB病毒(Epstien-Barr virus,EBV)感染是其主要致病因素,好发于儿童和青少年。 EBV是一种嗜淋巴细胞的双链 DNA 病毒,属于疱疹病毒科,主要经唾液传播,人群中感染率超过95%[4]。EBV感染后可在口腔咽部上皮细胞内增殖,引起呼吸道感染,并可长期潜伏在淋巴组织中。因此,其感染具有增殖性和潜伏性的特点,以非特异性表现为主,包括发热、扁桃体炎或咽峡炎等上呼吸道感染症状,同时伴有颈部淋巴结肿大和(或)外周血异型淋巴细胞增多等。规范治疗后多数患者预后良好[2-3]。 IM发病相对隐匿,临床表现复杂且无特异性,如果单纯依靠临床表现,常会误诊或漏诊。因此,寻找用于IM早期诊断的更为灵敏而有效的方法,尤为重要[5]。 根据《儿童EB病毒感染相关疾病的诊断和治疗原则专家共识》[1]关于传染性单核细胞增多症的诊断,共识主要涉及以下内容: IM的诊断标准: IM的诊断依据包括临床表现、原发性EBV感染的实验室证据和非特异性实验室检查。临床诊断病例需满足临床表现中任意3项及非特异性实验室检查中任意1项,确诊病例需满足临床表现中任意3项及原发性EBV感染的实验室证据中任意1项。 IM的诊断依据: 1、临床诊断病例:满足下列任意3项临床表现及任一项非特异性实验室检查。 2、确诊病例:满足下列任意3项临床表现及任一项原发性EBV感染的实验室证据。 根据以上检验结果及患者临床表现,参照《儿童EB病毒感染相关疾病的诊断和治疗原则专家共识》,西安区域医学检验中心实验室人员高度怀疑患者为传染性单核细胞增多症。随后和临床医生及患者家属进行沟通、回访,持续关注患者情况,医生根据检验结果对患者用药进行调整,治疗一天后体温恢复正常,病情缓解。 该病例通过血涂片复检淋巴细胞异常增高及异型淋巴细胞报警提示的血常规结果,综合分析血常规结果和生化、免疫检验结果,推断了患者可能为EB病毒感染,从而进行EB病毒检测,明确了病原学,最终结合临床推断了IM。因此,在血常规检测过程中,血涂片镜检是重要的一部分,血涂片复检在血常规检测中具有重要的意义,应该受到检验人员的重视,提高警惕性,从而提高检测的准确性,为医生诊断疾病和指导临床用药提供更有价值的信息。 西安区域医学检验中心核心实验室采用亚辉龙iFlash 3000化学发光免疫分析仪可以进行EB病毒六项检测、肺炎四项检测、优生优育(TORCH)十项测定等项目的检测,能满足基层医疗机构多项检测需求,助力老百姓在家门口享受到高质量的诊疗服务。 参考文献 [1] 中华医学会儿科学分会感染学组,全国儿童EB病毒感染协作组. 儿童EB病毒感染相关疾病的诊断和治疗原则专家共识[J]. 中华儿科杂志,2021,59(11):905-911. DOI:10.3760/cma.j.cn112140-20210618-00513. [2] 临床血液学检验/许文荣王建中主编.5版.北京:人民卫生出版社,2012. [3] 胡岩岩,潘家华,周浩泉.儿童传染性单核细胞增多症临床及实验室检查特点分析[J].中华全科医学,2021,19(09):1510-1513.DOI:10.16766/j.cnki.issn.1674-4152.002099. [4] 俞善春.EB病毒六项抗体联合检测对儿童传染性单核细胞增多症的诊断价值[J].基层医学论坛,2022,26(13):80-82.DOI:10.19435/j.1672-1721.2022.13.026. [5] 陈新敏,梁华,郭燕,何抒蔓,叶鑫梅,张跃川,蒋康.异型淋巴细胞比例联合EB病毒抗体及核酸检测在儿童传染性单核细胞增多症辅助诊断中的应用[J].国际检验医学杂志,2021,42(04):501-503. 撰文 | 普检部 冯芳芳 编辑 | 王志成 审核 | 李斌

亚辉龙iFlash 3000化学发光免疫分析仪